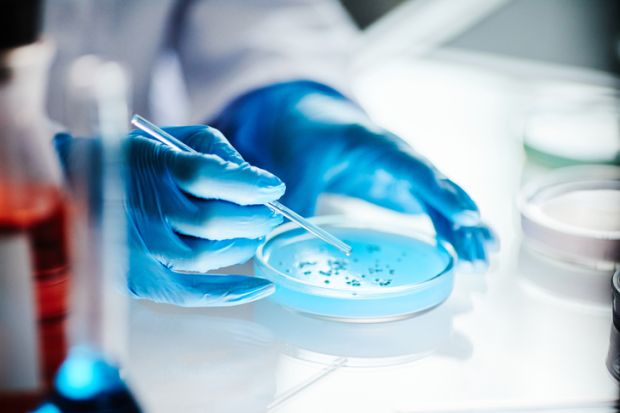
Scientists

An influential government advisory body’s review into the effectiveness of the UK’s immigration system in attracting top talent is under way.
The Migration Advisory Committee (MAC) announced on 5 March that it is launching a call for evidence on the Global Talent and Innovator Founder visa routes.
Analysis of the latest Home Office data shows that the two routes have faced contrasting success in recent years.
In 2025 there were 6,655 visas issued under the Global Talent scheme, a key route for bringing in leading scientists, which was broadly the same as the year before. This was 10 per cent below the peak of 2023 but well above the previous three years on record.
A quarter of visas issued were to recipients from China and the US. The number from both countries has increased elevenfold and fourfold respectively since 2020.
Visas for Indian applicants have remained consistently high over the past few years but the number from Russia has fallen 65 per cent since 2023.
Of the Global Talent visas issued in 2025, 59 per cent were for main applicants and 41 per cent for their family members.
The figures also show declining demand for UK jobs from experienced entrepreneurs. There were just 517 applications for innovator founder visas in 2025 – half the number as between 2021 and 2023 and the lowest number since 2019.
The volume of applications has fallen significantly since the peak year of 2023 across many key source countries, including Pakistan (58 per cent), India (64 per cent), and China (76 per cent).
The number of applications from China in 2025 (36) was only slightly more than the demand from Iran (33). In contrast, a record 79 applications from were from the US, which is now the largest source country.
When excluding dependants, just 203 main applicants were granted these visas last year.
The MAC review, which is chaired by Brian Bell, professor of economics at King’s College London, is expected to be completed by the winter.
It will cover how well set up the UK’s immigration system is to attract highly talented people to the UK, how effectively routes aimed at talent interact with each other and interact with other immigration routes, what talented migrants do when they get to the UK, and what economic and wider value they provide.
It will also review what constitutes global talent and the endorsement body model.
Applicants for the Global Talent visa must either have won an eligible prestigious prize, which includes awards such as the Faraday Medal, or be endorsed.
In a letter to the Home Office, Bell says attracting international global talent is a key government priority as set out in the immigration White Paper.
“It impacts the labour market and economic growth, and there are a number of talent related immigration routes, including the Global Talent visa. Alongside this, we acknowledge the government’s broader commitment to bringing down net migration.”
A recent MAC review of the skilled worker visa urged the government to abolish the discounts that allow PhD holders to qualify even if they earn below the salary threshold.
Register to continue
Why register?
- Registration is free and only takes a moment
- Once registered, you can read 3 articles a month
- Sign up for our newsletter
Subscribe
Or subscribe for unlimited access to:
- Unlimited access to news, views, insights & reviews
- Digital editions
- Digital access to THE’s university and college rankings analysis
Already registered or a current subscriber?